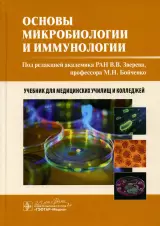

- Каталог
- Художественная литература
- Российская литература
- Зарубежная литература
- Кинороманы
- Фантастика. Мистика. Ужасы
- Детективы. Боевики. Триллеры
- Сентиментальная литература
- Приключенческая литература
- Комиксы. Юмор
- Поэзия
- Историческая литература
- Художественно-документальная проза
- Драматургия
- Фольклор
- Прочие издания
- Русская литература
- Современная литература
- Русская классическая литература XVIII-начала XX вв. (до 1917 г.)
- Советская литература (1917-1991 гг.)
- Русская литература XVIII-нач. XX вв. (до 1917 г.)
- Русская литература советского периода (1917-1991 гг.)
- Литература русского зарубежья
- Литература русского зарубежья (1917-1990 гг.)
- Древнерусская литература. XI-XVII вв.
- Древнерусская литература. Литература XIV-XVII вв.
- Сентиментальная проза
- Историческая проза
- Комиксы. Юмор. Манга. Артбуки
- Приключенческая проза
- Военная проза
- Юмор. Афоризмы
- Кинороманы. Новеллизация
- Юмор. Афоризмы
- Комиксы. Манга. Ранобэ
- Артбуки. Вселенные
- Юмор. Сатира
- Детская литература
- Художественная литература
- Обучающая и развивающая литература
- Обучение письму. Прописи
- Знакомство с окружающим миром
- Обучение счету. Основы математики
- Обучение чтению. Буквари
- Логика. Мышление
- Иностранные языки для детей
- Общее развитие
- Развитие речи
- Внимание. Воображение. Память
- Подготовка к школе. Тесты
- Демонстрационные материалы
- Творческое развитие
- Культура общения. Этикет
- Методики работы с детьми
- Другая обучающая литература
- Познавательная литература для детей
- Животные. Растения
- Религиозная литература для детей
- Окружающий мир
- История
- Психология для детей
- Техника. Транспорт. Промышленность
- Человек
- Культура. Искусство
- Универсальные словари и энциклопедии
- Доисторическая жизнь. Динозавры
- Физика. Химия. Математика. Биология
- География. Геология. Минералогия
- Наука. Изобретения
- Обществознание. Экономика. Право.
- Космос. Вселенная. Земля
- Земля. Космос. Вселенная
- Русский язык. Литература
- Информатика
- Мифология
- Универсальные энциклопедии и словари
- Спорт. Здоровый образ жизни
- Военное дело. Оружие
- Прочие издания
- Спорт. Здоровье и гигиена
- Религии
- Мода. Красота. Этикет
- Астрология. Мифология. Гадания
- География
- Детское творчество и досуг
- Книги для малышей (до 3-х лет)
- Книги для родителей
- Канцелярские товары
- Гуманитарные науки
- Психология
- Популярная психология
- Психотерапия
- Прикладная психология
- Практическая психология
- Психология личности. Характер. Личностный рост
- Социальная психология. Психология отношений. Коммуникации
- Глубинная психология. Психоанализ
- Социальная психология
- Детская психология
- Общая психология
- Психофизиология. Познавательные процессы (мышление, память и т.п.)
- Психологические школы и направления
- История
- Философские науки
- Искусство
- Литературоведение
- Языкознание. Риторика
- Культура. Культурология
- Военное дело. Оружие. Спецслужбы
- Психология
- Религии. Эзотерика. Оккультизм
- Эзотерика. Парапсихология. Тайны
- Гадания. Толкование снов. Тайны имени
- Эзотерические учения. Теософия
- Духовные практики
- Магия. Колдовство. Суеверия
- Астрология. Нумерология
- Астрология
- Эзотерические учения
- Парапсихология
- Тайны (таинственные явления в природе и истории)
- Пророчества. Ченнелинг. Спиритизм
- Знаки. Символы
- Фэн-шуй
- Пророчества. Ченнелинг
- Православие
- Христианство
- Другие религии и культы
- Ислам (мусульманство)
- Буддизм
- Религиоведение. История религий
- Религии Древнего мира
- Эзотерика. Парапсихология. Тайны
- Медицинская литература
- Клиническая медицина. Внутренние болезни
- Стоматология
- Кардиология. Гематология
- Гастроэнтерология. Эндокринология
- Гинекология. Акушерство
- Гинекология. Акушерство. Беременность
- Инфекционные и паразитарные болезни
- Дерматология. Венерология
- Онкология
- ЛОР. Оториноларингология. Пульмонология
- Офтальмология
- Урология. Нефрология
- Ревматология
- Внутренние болезни в целом
- Другие внутренние болезни
- Общая патология. Общая терапия
- Другие отрасли медицины
- Основы медицины. Система здравоохранения
- Анатомия и физиология человека
- Основы медицины. История медицины
- Организация здравоохранения
- Медицинская микробиология. Иммунология
- Гигиена и санитария. Эпидемиология
- Сестринское дело
- Основы медицинских знаний. История медицины
- Справочная и нормативная литература
- Здравоохранение
- Сестринское дело. Медицинский персонал
- Медицинская техника
- Дополнительное профессиональное образование
- Хирургия
- Педиатрия
- Фармакология. Токсикология
- Популярная и нетрадиционная медицина
- Общая медицина. Система здравоохранения
- Анатомия и физиология человека
- Основы медицины. История медицины
- Сестринское дело
- Медицинская микробиология. Иммунология
- Организация здравоохранения
- Гигиена и санитария. Эпидемиология
- Справочная и нормативная литература
- Информационные технологии в медицине. Телемедицина
- Медицинская техника
- Дополнительное профессиональное образование
- Медицинская микробиология. Иммунология. Аллергология
- Клиническая медицина. Внутренние болезни
- Общественные науки
- Педагогика
- Логопедия
- Дошкольное образование
- Коррекционная педагогика
- Общие вопросы
- Воспитательная работа. Организация досуга
- Педагогическая психология
- Общее среднее образование
- Методика преподавания
- Высшее образование
- Коррекционная педагогика. Дефектология
- Обучение взрослых. Самообучение
- Социальная педагогика
- Среднее специальное образование. Профессионально-техническое образование
- Обучение взрослых. Самообразование
- Военное дело. Гражданская защита
- Политика
- Политология
- История политической мысли
- Политические биографии. Воспоминания
- Государственное управление. Власть
- Современное политическое положение государств
- Политические партии и организации
- Избирательные технологии. Выборы
- Политические партии и движения
- Политические партии и организации. Общественные движения
- Международные отношения. Внешняя политика
- Социология. Демография
- Этнография
- Военное дело. Оружие. Спецслужбы
- Книговедение. Средства массовой информации
- Обществознание. Социология. Демография.
- Обществознание . Социология. Демография.
- Страхование. Социальное обеспечение
- Средства массовой информации
- Общественные науки . Социология. Демография.
- Эзотерика. Парапсихология. Тайны
- Педагогика
- Дом. Быт. Досуг
- Школьная литература
- Начальная школа
- ЕГЭ. ОГЭ. ВПР
- Средняя школа
- Единый государственный экзамен (ЕГЭ)
- Пособия для выпускников и абитуриентов
- ЕГЭ. ОГЭ
- ЕГЭ. Русский язык
- ЕГЭ. Математика
- ЕГЭ. Химия
- ЕГЭ. Биология
- ОГЭ. Обществознание
- ОГЭ. Физика
- ОГЭ. Математика
- ОГЭ. Информатика
- ОГЭ. Русский язык
- ОГЭ. Биология
- ЕГЭ. Иностранные языки
- ЕГЭ. История
- ОГЭ. География
- ЕГЭ. Физика
- ОГЭ. Химия
- ОГЭ. История
- ОГЭ. Литература. Культура речи
- ЕГЭ. Обществознание
- !!!Математика
- ЕГЭ. ОГЭ
- !!!География
- !!!История
- !!!Иностранные языки
- ЕГЭ. Информатика
- ЕГЭ. География
- ЕГЭ. Литература. Культура речи
- Справочная литература
- Художественная литература
- Иностранные языки
- Английский язык
- Китайский язык
- Немецкий язык
- Другие иностранные языки
- Другие иностранные языки
- Сербский, хорватский языки
- Иврит, идиш
- Персидский язык
- Армянский язык
- Грузинский язык
- Украинский язык
- Румынский язык
- Нидерландский язык
- Вьетнамский язык
- Датский язык
- Болгарский язык
- Казахский язык
- Азербайджанский язык
- Белорусский язык
- Венгерский язык
- Амхарский язык
- Чеченский язык
- Испанский язык
- Французский язык
- Японский язык
- Турецкий язык
- Корейский язык
- Арабский язык
- Итальянский язык
- Латинский язык
- Польский язык
- Португальский язык
- Греческий язык
- Чешский язык
- Хинди
- Шведский язык
- Финский язык
- Русский язык как иностранный
- Норвежский язык
- Древние языки
- Многоязычные словари и справочники
- Экономика. Экономические науки
- Бизнес. Предпринимательство
- Популярная литература по бизнесу
- История бизнеса. Мемуары и биографии бизнесменов
- Основы бизнеса
- Этика бизнеса. Деловое общение. Деловое письмо
- Отраслевой бизнес
- Туристическая и сервисная деятельность
- Основы предпринимательства
- Электронный бизнес
- Делопроизводство. Секретарское дело
- Средний и малый бизнес
- Электронная коммерция
- Недвижимость
- Этика бизнеса. Деловое общение
- Стандартизация. Сертификация. Управление качеством
- Коммерческая безопасность
- Менеджмент
- Психология управления
- Организационный и производственный менеджмент
- Общий менеджмент. Теория управления
- Управление персоналом. Мотивация
- Стратегический менеджмент
- Управление проектами
- Отраслевой менеджмент
- Антикризисный и риск-менеджмент
- Общий менеджмент
- MBA
- Консалтинг. Управленческое консультирование
- Консалтинг
- Экономика
- История экономических учений. Экономическая история
- Экономическая теория
- Мировая экономика. Международные экономические отношения
- Отраслевая экономика
- Экономика зарубежных стран
- Экономический анализ
- Экономика России
- Цифровизация. Информационные системы в экономике
- Экономика предприятия (фирмы)
- Экономическая география. Региональная экономика
- Планирование и прогнозирование экономики
- Макроэкономика
- Государственное регулирование экономики
- Микроэкономика
- Мировая экономика
- Финансы
- Инвестиции
- Деньги. Денежное обращение
- Биржевое дело
- Финансы. Кредит
- Финансовый анализ, учет и планировние
- Финансовый менеждмент
- Банковское дело. Кредитная система
- Ценные бумаги. Фондовый рынок
- Международные финансовые отношения
- Финансы предприятий
- Электронные деньги. Криптовалюта
- Финансовый анализ, учет и планировнаие
- Ценные бумаги
- Банковское дело
- Бюджетная система
- Государственные и муниципальные финансы
- Аренда. Лизинг
- Маркетинг. Реклама. Связи с общественностью
- Торговля. Продажи
- Бухгалтерский учет. Аудит
- Труд. Экономика труда
- Налоги и налогообложение
- Статистика
- Внешнеэкономическая деятельность
- Бизнес. Предпринимательство
- Естественные науки. Математика
- Математика
- Общие вопросы математики
- Высшая математика
- Математический анализ. Функциональный анализ
- Теория вероятностей. Математическая статистика
- Геометрия
- Алгебра
- Вычислительная математика. Математическая кибернетика
- Теория чисел. Арифметика
- Основания математики. Математическая логика
- Основания математики. Математическая логика
- Топология
- Исследование операций
- Биологические науки
- Науки о Земле
- Страноведение. Краеведение
- География. Географические открытия
- Геология. Полезные ископаемые. Геохимия
- Страноведение. Краеведение. Регионоведение
- Геодезия. Картография. Топография
- Общие вопросы наук о Земле
- Геодезия. Картография
- Гидрология. Океанология
- Метеорология. Климатология
- География
- Физика земли. Сейсмология
- Геология. Полезные ископаемые
- Физика
- Естественные науки в целом
- Химические науки
- Астрономия. Космология
- Экология
- Астрономия
- Математика
- Комиксы. Артбуки
- Прикладные науки. Техника
- Транспорт
- Другие отрасли промышленности
- Нефтегазовая промышленность
- Металлургия
- Другие отрасли промышленности
- Лесная и лесохимическая промышленность
- Химическая промышленность
- Горная промышленность
- Горнодобывающая промышленность
- Лесохимическая, деревообрабатывающая, целлюлозно-бумажная промышленность
- Легкая промышленность
- Ювелирное дело
- Полиграфия
- Энергетика
- Радиотехника. Электроника. Связь
- Машиностроение. Приборостроение
- Строительство
- Технические науки
- Сельское хозяйство. Ветеринария
- Пищевая промышленность.
- Производственная безопасность
- Нанотехнологии
- Безопасность жизнедеятельности
- Право. Юридические науки
- Нормативные правовые акты. Справочная литература
- Криминология. Криминалистика
- Право в целом. История и теория государства и права
- Гражданское право
- Общие вопросы гражданского права
- Предпринимательское право. Коммерческое право
- Семейное право. Наследственное право
- Авторское право. Патентное право. Информационное право
- Обязательственное право. Договоры
- Медицинское право
- Жилищное право
- Потребительское право
- Право собственности и другие вещные права
- Транспортное право
- Защита прав потребителя
- Уголовное право
- Конституционное (государственное) право. Административное право
- Правоохранительные органы
- Гражданское процессуальное право. Судоустройство
- Международное право
- Финансовое право
- Трудовое право. Право социального обеспечения
- Земельное право. Экологическое право
- Другие отрасли права
- Таможенное право
- Компьютерная литература
- Языки и среды программирования
- Графика, дизайн, мультимедиа, игры
- Общие вопросы
- Администрирование. Защита информации
- Бизнес-приложения
- Компьютерные сети. Интернет
- Операционные системы
- Базы данных
- MS Office. Офисные программы Microsoft
- Системы проектирования (CAD/CAM)
- Аппаратное обеспечение
- Информатика. Информационные технологии
- Радиотехника. Электроника. Связь
- Художествено-документальная проза
- Искусство
- Справочные издания
- Универсальные словари и энциклопедии
- Общая психология
- Политология
- Универсальные словари и энциклопедии
- Фотография
- Основы медицинских знаний. История медицины
- Наука. Науковедение
- Древний мир
- Невропатология. Психиатрия
- История религий
- Общие работы по физике
- Общая биология
- Изобразительное искусство
- Творческие биографии писателей и литераторов
- Экономическая теория
- Общие вопросы математики
- Архитектура
- Спорт. Здоровый образ жизни
- Основы медицины. История медицины
- Фольклористика
- Напитки. Домашнее виноделие
- Основы философии
- Справочная и нормативная литература.Комментарии
- Универсальные словари и энциклопедии
- Подарочная продукция
- Художественная литература
- Новинки
- Бестселлеры
- Детям
- Не книги
- Развивающие игры
- Рисование. Роспись
- Развивающие игры
- Набор для рисования. Роспись
- Пазлы (до 50 элементов)
- Набор для лепки
- Мозаики
- Семейные игры
- Набор для аппликаций, коллажей
- Логические игры
- Набор для создания украшений. Вышивание, вязание, плетение
- Карточные игры
- Музыкальные игрушки и инструменты
- Деревянные конструкторы
- Архитектура
- Набор для исследований и опытов
- Пластиковые конструкторы
- Деревянные пазлы
- Прочие
- Куклы и аксессуары для кукол
- Поделки из бумаги
- Набор для создания поделок с магнитами
- Конструктор из бумаги и картон
- Магнитные буквы, цифры, игры
- Набор для росписи по дереву
- Поделки из дерева. Выжигание
- Шнуровки
- Набор для рисования песком
- Автомодели
- Книжки-игрушки
- Украшения, аксессуары
- Декорирование для детской
- Мягкие конструкторы
- Кубики
- Изготовление свечей
- Стратегические игры
- Военная техника
- Викторины
- Домино, лото
- Судомодели
- Металлические конструкторы
- Головоломки
- Набор для создания барельефа
- SLIME. Слизь
- Набор для создания гравюры
- Экономические игры
- Шахматы, шашки, нарды
- Пазлы (от 50 до 100 элементов)
- Сортеры и лабиринты
- Авиамодели
- Военно-исторические миниатюры
- Объемные пазлы
- Интерьерные миниатюры
- Набор для создания фресок
- Наборы для лепки
- Мозаика
- Обучающие электронные игры
- Ж/д модели
- Лепка из гипса
- Игровые центры
- Электронные плакаты
- Витражи
- Игрушки для купания
- Игры. Развлечения
- Прочее
- Шитье
- Настольные игры
- Игрушки для активного отдыха, спорттовары
- Игры для праздников
- Детские игры
- Аксессуары для моделирования
- Детская психология
- Наборы для исследований и опытов
- Пазлы (от 100 до 500 элементов)
- Аксессуары и материалы для рукоделия
- Кукольный и настольный театр
- Мыло своими руками
- Подарочные наборы
- Организация праздников
- Мягкие игрушки
- Мастерим своими руками
- Развивающие коврики
- Канцтовары
- Ежедневники и записные книжки, блокноты
- Ежедневники, бизнес-блокноты, органайзеры
- Блокноты, записные книжки, блоки для записей
- Записные тематические книжки
- Рисование
- Дневники. Читательский дневник
- Анкеты, дневники
- Тетради
- Для записи кулинарных рецептов
- Тетради для нот
- Для записи иностранных слов
- Блоки, доски для записей
- Альбомы для рисования
- Бумага офисная
- Закладки для книг
- Аксессуары для документов
- Бланки
- Открытки, грамоты, дипломы
- Пеналы
- Материалы для творчества
- Дневники для музыкальной школы
- Чехол для карт
- Пленка стрейч
- Клейкая лента
- Тематические альбомы, дневники
- Картонные коробки
- Психология личности. Характер. Личностный рост
- Маркерные доски
- Аксессуары для подарков
- Фартуки для уроков труда
- Популярная психология
- Магия. Колдовство. Суеверия
- Учебная литература
- Открытки
- Подарочная продукция
- Икона из дерева
- Для дома, сада и интерьера
- Подарочные наборы
- Аксессуары для подарков
- Украшения к Новому Году
- Магия. Колдовство. Суеверия
- Нехудожественная литература
- Для книг
- Праздничное оформление
- Активный отдых, путешествия
- Значки
- Декративные элементы для авто
- Кухонные принадлежности. Посуда
- Открытки, письма Деду Морозу
- Маски для сна
- Планнинг
- Церковная утварь
- Рюкзаки, ранцы, сумки
- Футболки
- Часы, статуэтки, настенное панно
- Картины, постеры
- Бытовая химия
- Салфетки для уборки
- Губки для мытья посуды
- Мешки, пакеты для мусора
- Перчатки хозяйственные
- Фольга, пленка пищевая
- Средства для прочистки труб
- Пятновыводитель, отбеливатель
- Пакеты пищевые. Форма, пакетик для льда
- Швабры, насадки для швабры. Тряпки для пола
- Губки хозяйственные
- Ролики для чистки одежды, сменные блоки
- Бумага для запекания, выпечки
- Универсальное чистящее средство
- Пакеты, рукава для запекания
- Мыло для стирки
- Мочалки, губки для тела
- Аксессуар для ухода за полостью рта
- Салфетки для посуды
- Туалетное мыло
- Детский пятновыводитель, отбеливатель
- Набор для уборки дома
- Чистящие средства для кухни
- Средство для стирки
- Жидкие срества для стирки
- Игры
- Детское творчество
- Интерактивные игрушки
- Развивающие игры
- Рейтинги
- Блог